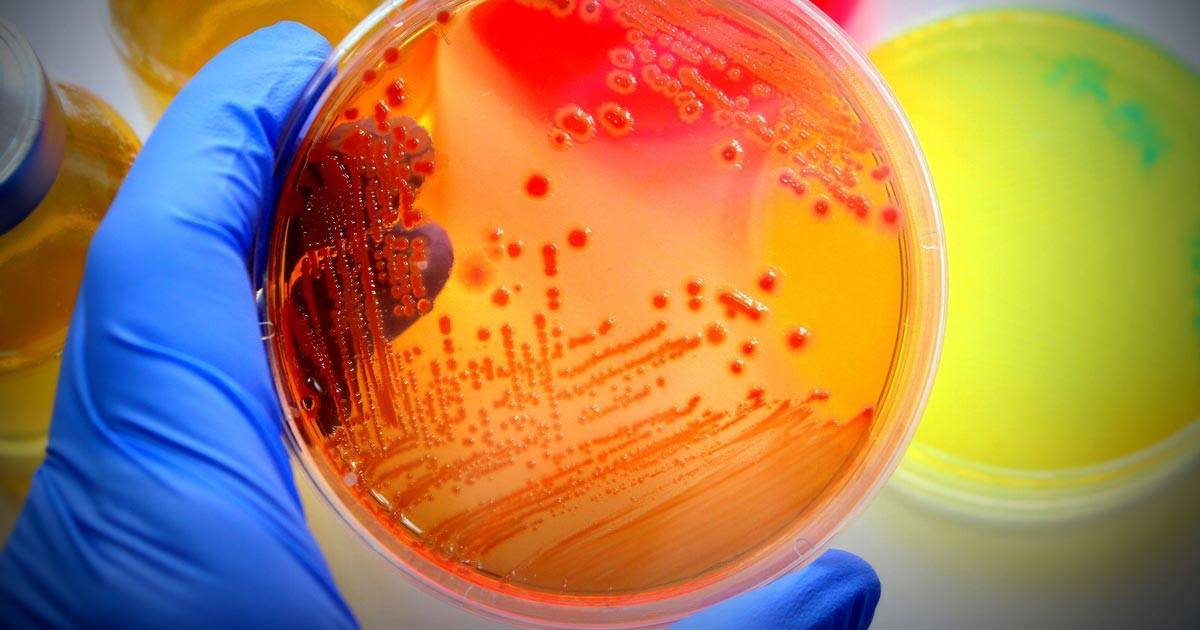

Противопоказания к применению зеленого чая
- Качество продукта. Для глаз надо только самое лучшее. Максимум полезности удается извлечь только из качественного крупнолистового зеленого чая. Меньше всего прока от мелких крупинок чая в виде гранул, кроме того, пылинки могут попасть в глаза и повредить слизистую. Вариант с пакетиками тоже неплох, если в них не очевидный чайный мусор, не приносящий никакой пользы. Цвет хорошего чая — светло зеленый, фисташковый — лучший сорт, темный, грязно-зеленый — испорчен либо пересушен.
- Нежелательные добавки. Чистый зеленый чай не аллергичен для подавляющего большинства людей, не наносит вреда коже. Но добавки в нем в виде ароматизаторов, частичек фруктов, цветочных лепестков могут быть вашим антигеном или слишком грубыми для тонкого эпидермиса под очами.
- Наличие кофеина. Кофеина в зеленом чае больше, чем в натуральном кофе. Поэтому воздержитесь от косметических процедур на его основе непосредственно перед сном. Если вы очень чувствительны к алкалоидам, то прилив бодрости некстати лишит вас сна.
- Цветовой пигмент. Цвет зеленого чая не столь ярко выражен, как черного, но он становится насыщенным при заваривании кипятком. Соблюдайте указанное в рецептах время воздействия примочек (компрессов), иначе синяки под нижними веками приобретут новый оттенок, особенно если кожа наделена аристократической бледностью. Обычно достаточно 10-15 минут, можно повторять процедуру несколько раз в день.
- Подсушивающий эффект. Любые водные растворы ведут к подсушиванию эпидермиса, в том числе и заварка. Выход есть — возьмите за правило после чайной церемонии промокнуть кожу салфеткой и нанести под нижние веки ваш привычный крем. Если вы боретесь с темными кругами, то он должен быть глубокого увлажнения, тонизирующий или антивозрастной. Если хотите убрать мешки и припухлость, то отдайте предпочтение тонизирующему крему с эффектом против признаков усталости и отечности век.
Важно! Не стоит проводить чайные процедуры для глаз в зимнее время перед выходом на улицу. Насыщенная влагой кожа плохо перенесет мороз.
Лучшие народные методы
Есть много народных рецептов, которые позволяют быстро вылечить ячмень на глазу. Многими из них можно дополнить медикаментозное лечение, назначенное врачом.
Прогревание
На начальной стадии ячмень хорошо лечится прогреваниями. Греть место воспаления можно лишь сухим теплом. Для этой процедуры можно использовать:
- Нагретую на сковороде соль. Её пересыпают в хлопковый мешочек и прикладывают к проблемному веку на 15 минут, до 6 раз за сутки.
- Отваривают яйцо, не остужая, заворачивают его в хлопковый платок и прикладывают к веку. Держать сухое тепло следует, пока яйцо не остынет.
- Если дома есть синяя лампа, то для лечения можно использовать её. Глаза прикрывают и на больное веко направляют тепло, расстояние между лампой и лицом должно быть не меньше 30 см.
Прогревания рекомендуется начинать проводить, когда только появляется лёгкий зуд на веке. Если гнойник уже созрел, делать такую процедуру категорически запрещено, так как она может привести к ухудшению состояния.
Настои
Лечить ячмень на глазах можно различными настоями, приготовленными на основе лекарственных трав. Такое лечение хорошо помогает на всех этапах болезни:
- Настой тысячелистника. Столовую ложку травы заливают стаканом кипятка и выдерживают 20 минут. После этого процеживают и применяют настой для примочек и промывания глаз.
- Настой шалфея. Заваривают точно так же, как и тысячелистник. Полученным настоем протирают больной глаз несколько раз в сутки. Для заваривания можно использовать траву в пакетиках.
- Настой календулы. Такой состав помогает быстро снять отёчность и воспаление. Настоем рекомендуется промывать глаза перед использованием лекарственных препаратов.
Использовать настои из лекарственных трав можно только в тёплом виде. Сразу готовят настои с запасом, хранят в холодильнике и перед применением подогревают.
Отвар ромашки
Самым эффективным средством для лечения ячменя на начальной стадии является отвар ромашки. Заваривают траву из расчёта полная десертная ложка на стакан воды. Отвар настаивают на протяжении 20 минут, после чего процеживают, хорошо отжимая жмых.
Отвар используют для промывания глаз каждые два часа и для примочек
Важно, чтобы отвар ромашки был тёплым и свежим, хранить его можно не больше суток в прохладном месте
Для удобства можно использовать готовые пакетики-саше, которые продаются в аптеке. Их заваривают из расчёта – 1 пакетик на половину стакана воды.
Чайная заварка
Для лечения ячменя в домашних условиях хорошо подходит крепкая чайная заварка. Её можно использовать для промывания глаз и примочек. Благодаря такому средству удаётся быстро устранить отёк и воспаление. Если начинать делать примочки с заваркой с первых дней болезни, то выздоровление будет очень быстрым.
Для лечения нужно отварить яйцо вкрутую и завернуть его в хлопковый платочек. Тепло прикладывают к проблемному глазу на 20 минут, яйцо регулярно переворачивают.
Для лечения можно использовать как морскую, так и кухонную соль. Для этого её подогревают на сухой сковороде и пересыпают в полотняный мешочек. Прикладывают тепло к больному глазу на 20 минут. Согревающие процедуры можно проводить несколько раз в день.
Если мешочек с солью слишком горячий, его следует дополнительно обернуть салфеткой. Тепло, приложенное к веку, должно быть комфортным.
Лечить ячмень на глазу дома можно и при помощи ржаного хлеба. Для этого берут мякоть, добавляют горячую воду и перемешивают, чтобы получилось густое тесто. Прикладывают его к проблемному глазу и выдерживают 15 минут. Благодаря таким компрессам можно уменьшить воспаление и боль.
Чеснок
Чеснок издавна используют для лечения кожных заболеваний, отлично помогает он и при ячмене на глазу. Есть несколько рецептов, которыми можно лечить нарыв:
- Зубчик чеснока измельчают на тёрке и отжимают сок. Смачивают в нём ватную палочку и аккуратно смазывают головку ячменя. Проводить процедуру нужно 2 раза в день.
- Два зубка чеснока режут на мелкие кусочки и проваривают в небольшом количестве воды до готовности. В полученном отваре смачивают кусочки стерильного бинта и прикладывают к больному глазу.
Стоит учитывать, что чесночный сок сильно раздражает слизистую, поэтому несколько минут будет ощущаться сильное жжение. Это является нормой, и отмены лечения не требует.
Лавровый лист
Берут 3-4 штуки лаврового листа и отваривают его на протяжении 15 минут на слабом огне. Отвар настаивают полчаса, смачивают в нём ватные диски и прикладывают к глазам. Отвар обладает выраженным противовоспалительным и дезинфицирующим действием.
Листик алоэ промывают водой и перекручивают на мясорубке. Полученную кашицу заворачивают в кусочек бинта и прикладывают к больному веку на 20 минут. Проводить такие процедуры следует 2 раза в сутки.
Уход с пользой за кожей вокруг глаз
Чай может решать многие проблемы в комплексе, но для косметических целей лучше использовать чай листовой или аптечный в пакетиках, чтобы «выжать» из него максимум пользы.
Компрессы делают поочередно с прикладыванием холодного и горячего ватного диска
Перед применением любого компресса из чая, лучше всего «подготовить», промыть кожу век, то есть провести контрастное умывание – достаточно сделать по 5 чередований холодной и горячей воды, чтобы перейти к следующим процедурам.
Правильное применение примочек от отеков и синяков с помощью чайных пакетиков
Полезно заваривать шалфей и цветки ромашки аптечной
Чтобы убрать синяки и отёки под глазами можно использовать пакетики чая, лучше включающие в себя травы, ромашку, шалфей для усиления эффекта (при отсутствии аллергии на данные добавки из трав). Главное, чтобы это были натуральные травы без ароматизаторов и красителей.
- Лучше всего с синяками и отёками справляется зелёный чай. Но он имеет тонизирующее действие. В составе присутствует кофеин, поэтому процедуру лучше проводить утром. Пакетик заливается кипятком 200 мл и настаивается до полного охлаждения. Пакетики прикладываются на нижние части век, и компресс выдерживается 15-20 минут.
- Контрастные процедуры хороши не только перед началом использования компрессов, но и после. Для этого заранее нужно разлить крепкий заваренный чай в формочки для льда и заморозить его. Затем прикладывать чайный лёд на припухшую область век, а затем тёплый пакетик чая. Чередовать по минуте в течение 6 минут, если лёд прикладывать слишком чувствительно, можно замотать его в слой марли.
Лечение крепкой заваркой
Для лечения заваркой лучше брать зеленый чай
Свежий листовой чай привнесёт более ощутимый эффект, чем от пакетиков, ведь в них добавляется уже переработанный вариант.
Поэтому лучше использовать чай листовой для приготовления примочек – времени и усилий понадобится больше, но и эффект очевиднее. Чтобы всегда быть с чистыми глазами и избежать попадания чаинок в глаза, после остывания нужно процедить настой через мелкое сито, а потом использовать по назначению:
- 2 столовые ложки зелёного чая заливаем 200 мл кипятка, накрываем крышкой, «укутываем» полотенцем и даём настояться до остывания. Процеживаем настой, окунаем в него ватные диски, пропитываем их и накладываем на глаза на 15 минут.
- В 100 мл крепкого чёрного чая добавляется 1 чайная ложка пищевой соды и чайная основа перемешивается: сразу необходимо смочить в ней ватные диски и приложить на отёчную область на 15 минут.
- В остывшую заварку: на 20 грамм чёрного крупнолистового чая 120 мл кипятка, добавляется измельчённый корень петрушки 10 граммов, масса перемешивается и процеживается. С помощью ватных дисков накладывается компресс на 10-15 минут 3 раза в течение дня.
Промывание и умывание зеленым чаем
Умываться нужно по утрам слабым настоем из травяного чая
Проведённые исследования показывают, что находящиеся в составе чая полифенолы в 18 раз действуют сильнее, чем витамин Е, поэтому пить чайный настой и умываться чаем – неотъемлемая часть утреннего моциона для сохранения здоровья и свежести кожи лица.
Использование зелёного чая для умывания:
- 30 грамм листьев чая заварить стаканом кипятка и выдержать полчаса до полного остывания. Затем нужно процедить напиток и поставить его в холодильник, глаза промывать в течение суток утром и вечером.
- Для умывания также подходит настой чая с добавлением чайной ложки мёда и сока лимона, при умывании тон кожи выравнивается, уменьшается раздражение и покраснение на коже.
- Для создания косметического чая также можно добавлять эфирные масла: масло розового дерева, чайного дерева или персиковое масло.
https://youtube.com/watch?v=lu-XqPVoy-o
Как лечить компрессами от покрасневших или уставших глаз
Когда глаза покраснели и очень болят по неизвестной причине или виною всему работа за компьютером, с этой проблемой легко справится чай, причем необязательно делать промывку длительно, чаще всего одного дня достаточно, чтобы вернуть свежесть взгляда.
Народные средства против покраснения кожи век
Промывание следует делать, используя пакетик или свежезаваренный и остуженный до комнатной температуры чай:
- Нужно лечь, намочить спонж чаем и аккуратно провести от наружной стороны века к внутренней, а затем, чистым спонжем промокнуть лишнюю жидкость.
- Таких повторений нужно сделать не менее трех-четырех, чтобы результат не заставил себя долго ждать.
Полезные свойства зеленого чая
Наиболее часто источниками проблемы являются следующие факторы повседневной жизни:
- Недостаточно продолжительный, некачественный сон на неудобной подушке, затянувшийся период переутомления, бессонница;
- Нездоровое питание с обилием жирной, острой, соленой пищи, злоупотребление алкоголем;
- Курение, длительное пребывание в задымленном помещении в компании курильщиков;
- Избыточная масса тела, ожирение, употребление большого количества углеводов;
- Несбалансированное питание, постоянный недостаток витаминов, сезонный авитаминоз;
- Пребывание в состоянии страха, депрессии, стрессы, накопившиеся негативные эмоции — волнение, тревожность, обида;
- Злоупотребление ультрафиолетом, сильный загар;
- Использование косметики плохого качества или не предназначенной для ухода за кожей вокруг глаз, нанесение специального крема непосредственно на ночь (рекомендуется за 30 минут до сна);
- Поздний ужин, обильное питье на ночь;
- Ночные бдения за компьютером, перед телевизором, занятие рукоделием при плохом освещении;
- Плохая наследственность, заболевания эндокринной системы, гормональные изменения.
- Нормализует обмен веществ в коже. Флавониды упорядочивают обменные процессы в коже. Являясь эрготропным продуктом, благоприятствующим похудению, чай повышает энергетический тонус дермы, способствует расщеплению жировой клетчатки.
- Стимулирует выработку коллагена. Кожа под глазами становится более плотной, подкожная мембрана менее пористой, постепенно исчезают синяки и отеки, разглаживаются незначительные морщинки.
- Улучшает кровообращение. Витамин Р в составе зеленого чая — природный «омолодитель», особенно полезен зрелой коже. Он укрепляет стенки капилляров, делает их здоровыми. Устраняется застой лимфы в тканях, жидкость не скапливается под кожей, образуя отеки под глазами, а выводится из этой зоны. Одновременно дерма тонизируется, укрепляется.
- Увеличивает защитные свойства кожи. Деликатная кожа вокруг глаз становится более упругой, здоровой, возрастают ее способности противостоять негативному влиянию окружающей среды.
- Борется с преждевременным старением и увяданием кожи. Со временем дерма под глазами истончается, увядает, под ней заметнее капилляры. Под воздействием зеленого чая этот процесс замедляется, улучшается взаимодействие клеток, и питательные вещества насыщают кожу. Она «молодеет», дольше остается плотной, свежей и эластичной.
- Увлажняет, смягчает и разглаживает кожу. Сухость кожи под глазами — следствие отсутствия в ней жировых, мышечных волокон, увлажняющих желез. Прикладывая заварку зеленого чая под глаза, мы восполняем недостаток влаги. Снабжение кожи кислородом — отличное профилактическое средство против отечности.
- Улучшает цвет кожи. Уставшая кожа приобретает сероватый цвет, проступающие сквозь нее капилляры добавляют нездоровую желтизну или синюшный оттенок. Зеленый чай освежает дерму, делает отдохнувшей, светящийся. За счет улучшения циркуляции крови в сосудах и капиллярах происходит ее приток к покровным тканям, возвращая природное сияние.
- Успокаивает и снимает воспаление. Отечность и синева под глазами, возникшая после длительного пребывания в несвойственном глазам режиме (на солнце, перед компьютером, у огня, в пыли или дыму), сопровождается шелушением, раздражением кожи. Эфирные масла чая способствуют быстрому ее заживлению, нейтрализуют отрицательное влияние разного рода излучений, устраняют раздражение и, следовательно, отеки.
Важно! Убедитесь, что мешки и темные круги под глазами — это отпечаток неправильного образа жизни или наследственность, а не внешнее проявление заболевания (сердце, почки, эндокринная система), требующего незамедлительного лечения. Обязательно посетите врача терапевта и эндокринолога, особенно если возраст старше 35, чай в этом случае не поможет.
Виды эффективного чая для лечения
Для устранения конъюнктивита подходит чёрный и зелёный чай. Главным помощником выступают дубильные вещества, содержащиеся в заварке.
Справка: Доказано, что наибольшее количество дубильных веществ содержится в листовом зеленом чае (до 30%).
Использование чёрного чая некритично — в такой заварке содержится 17% дубильных веществ, чего достаточно для борьбы с конъюнктивитом. Многие используют рецепт наших предков из Древней Руси. Он заключается в настаивании чёрного чая целый день перед применением. Современные врачи рекомендуют в лечебных целях свежезаваренный чай. Какой из способов выбрать? Поможем вам подобрать эффективные варианты!

Распространённым средством против конъюнктивита является ромашковый чай. Лечебные свойства ромашки идеально подходят для борьбы с симптоматикой болезни. Основные симптомы недуга:
- краснота;
- жжение;
- слезоточивость;
- отёк;
- гной.
Ромашка — это успокоительное средство при жжении и отёках, она также дезинфицирует и действует обезболивающе. Антибактериальные свойства ромашки не дают очагу распространяться, поэтому использование ромашкового чая оказывает восхитительный эффект на ранних стадиях заболевания.
Высокой эффективностью отличается чай из шиповника, особенно если конъюнктивит вызван вирусом.
Какой бы вид чая вы ни выбрали, главное — его натуральность. Не используйте чай с химическими ароматизаторами и добавками. Они малоэффективны и наносят серьёзный вред здоровью. Ароматизаторы способны вызвать сильнейшую аллергическую реакцию. Помните, что глаз — необычайно нежный орган.
От каких болезней помогают примочки
Глазные болезни не всегда сопровождаются серьёзными последствиями, иногда достаточно на ранней стадии покраснения обратиться к «чайному методу» и устранить причиненный вред в корне:
- Ячмень можно лечить и нужно испробовать для этих целей чай, особенно хорошо помогает способ прикладывания тёплых чайных пакетиков к зоне воспаления до момента, когда пакетик приобретет температуру тела. Затем нужно поменять компресс и повторить действия 2-3 раза за один приём.
- Конъюнктивит, особенно в хронической стадии можно лечить чаем — заварить 30 грамм на стакан кипятка, процедить и отлить в отдельную ёмкость 1/3 настоя. Стерильными спонжами, смоченными в чае протирать от внешнего уголка глаза к внутреннему несколько раз, остаток чая вылить и в течение дня повторить процедуру еще 2 раза, с новыми спонжами.
Лечение бактериального конъюнктивита
Также применяются антибиотики. Лечение бактериального конъюнктивита чайной заваркой бессмысленно. В первую очередь необходимо подавить размножение бактерий.
Так называемые народные средства, различные примочки, компрессы, промывания отварами не способствуют уничтожению микробов. Однако компрессы, сделанные с помощью чайной заварки, помогают немного ослабить симптомы болезни — зуд, жжение, боль, рези. Помогают они и уменьшить отеки. Но более эффективными являются капли на основе природной слезы. Они действуют мгновенно, устраняя почти все признаки воспаления.
Зеленый и черный чай могут использоваться в качестве дополнительного средства. Многие прибегают к такому методу лечения конъюнктивита, чтобы избавиться от отеков и отправиться на работу. Но при бактериальной инфекции необходимо взять больничный. Во-первых, больной заразен и опасен для окружающих. Во-вторых, состояние может ухудшиться, в результате чего заболевание станет хроническим.
Промывания глаз детям
Промывание глаз — неотъемлемая часть утреннего туалета новорожденного ребенка. Главное не занести при проведении процедуры инфекцию, тщательно мыть руки и пользоваться стерильным материалом.
Если глазки чистые, нет необходимости использовать специальные растворы или настои. Достаточно промыть глаза грудничка теплой водичкой, очень слабой заваркой черного или зеленого чая.

Для детей используют только рассыпную заварку, не пакетики
Если у малыша сильно слезятся глаза, готовят травяные чаи на основе ромашки, календулы, шалфея, липы. Для этого 1-1,5 ложки лекарственного растения или смеси трав заливают стаканом кипятка и настаивают около часа. Затем промывают каждый глазик, следуя алгоритму промывания глаз для взрослых.
Детям старше 3-4 месяцев протирание можно заменить закапыванием.
Важно! При появлении корочек на веках, покраснении слизистых, гнойных выделениях, припухлостях век, немедленно обращаются к врачу. Начиная с 5-6 лет детей обучают проводить необходимые гигиенические процедуры с глазами самостоятельно
Примочки и регулярное промывание чаем особенно необходимы с началом учебы, когда нагрузка на глаза увеличивается
Начиная с 5-6 лет детей обучают проводить необходимые гигиенические процедуры с глазами самостоятельно. Примочки и регулярное промывание чаем особенно необходимы с началом учебы, когда нагрузка на глаза увеличивается.
Как делаются примочки
Чайные компрессы полезны и не требуют вложения существенных средств или усилий. Чтобы они дали нужный результат, учитываются рекомендации:
- желательно пользоваться крупнолистовым чаем для заварки, который не подвергался на производстве термической обработке, поэтому в нем сохранении активные вещества и полезные характеристики;
- приобретается только обычный чай, поэтому в нем не должно быть ненужных добавок, кусочков фруктов, специй или ароматизаторов;
- компрессы делаются утром или днем, так как если сделать их вечером, то это приводит к чрезмерному тонизирующему эффекту;
- держатся на глазах пакетики максимально в течение 20 минут, а иначе кожа потемнеет.
Внимание! Для борьбы с мешками или синяками под глазами делаются холодные примочки
Из чайных пакетиков
С помощью пакетиков легко делаются компрессы, позволяющие бороться с несовершенствами кожи или заболеваниями слизистой оболочки. Чай обладает антисептическими свойствами, поэтому легко снимает усталость и воспалительные процессы. Если человек болеет, то такие компрессы позволяют бороться с конъюнктивитом.
При использовании чайных пакетиков выполняются действия:
- в кружку заливается кипяток;
- в него опускаются пакетики;
- остывшие теплые чайные пакетики укладываются на глаза;
- в таком состоянии они оставляются на 15 минут.
Уже через три процедуры отмечается положительный эффект. Использование пакетиков безопасно для взрослых и детей. Во время обострения гриппа целесообразно пользоваться такими компрессами для профилактики простудных заболеваний.
Если приходится бороться с ячменем, то теплый пакетик прикладывается только к больному глазу, причем желательно делать несколько подходов. Так как в заварке присутствует таниновая кислота, то оказывается антибактериальное воздействие. Поэтому буквально после одной процедуры снимается отек.
Из листового чая
Из него делается заварка, в которой смачивается ватный тампон, наносящийся непосредственно на глаза. Поэтому для создания компресса выполняются действия:
- на 1 стакан кипятка берется 2 столовые ложки заварки;
- желательно брать листья зеленого или ромашкового чая;
- после остывания настоя, в него опускаются ватные диски;
- изделия немного отжимаются, после чего укладываются на глаза.
Такой компресс держится на веках около 10 минут. Если используется черный чай, то на стакан кипятка желательно пользоваться 3 столовыми ложками листьев. Но такая заварка не обладает целительными свойствами, которые присущи зеленым листьям. Обычно в продукции содержатся красители, изменяющие цвет кожи возле глаз.
Из зеленого чая
Использование зеленых чайных листьев для примочек идеально для борьбы с воспалениями или отеками. Исследования показывают, что в их составе содержится полифенолы, позволяющие сохранить здоровье и свежесть кожи.
Для создания примочек делается заварка, для чего листья заливаются кипятком. Для полного остывания раствора требуется около 30 минут. Для усиления эффекта в заварку добавляется немного меда или лимонного сока. Если раствор используется для умывания, то это снимает раздражение и убирает красные пятна на коже. Нередко делаются специальные компрессы, в которых чай сочетается с эфирными маслами.
Он считается загадочным напитком, обладающим целебными свойствами. Его можно не только пить, но и использовать для компрессов. Он делается из чайных листьев, но основное отличие заключается в способе обработки. Напиток представлен перебродившей заваркой. Он обладает специфическим вкусом и запахом, но идеально подходит для примочек.
Чтобы заварить пауэр, используется небольшой глиняный чайник, который заполняется водой. Емкость кипятится в течение трех раз, причем после каждого раза сливается немного воды. Далее вода размешивается в центре для получения воронки. Именно в нее высыпаются подготовленные листья. После закипания жидкости, чайник снимается с плиты. Пользоваться напитком для примочек можно после того, как опустятся все чаинки.
Кубики льда
После компрессов остается много заварки, которая может использоваться в будущем. Для этого она выливается в специальные формочки для льда, которые укладываются в морозилку. Готовые кубики используются для протирания кожи вокруг глаз.
Внимание! Этот метод не может применяться людьми, страдающими куперозом или имеющими сосудистую сеточку
Эффективность чайных примочек
Примочки из чая – доступный способ для устранения усталости глаз, синяков и отеков, ингредиенты есть в каждом доме.
Преимущества народного метода:
- компоненты есть в продаже во всех магазинах и аптечных организациях, в доме каждой хозяйки;
- снимает отечность и воспаление;
- помогает при воспалительных заболеваниях глаз, применяется как дополнительное средство, удаляет корочки с век и гнойные выделения;
- черный чай, другие сорта широко применяются для кожи лица, поскольку обладают антисептическим, противовоспалительным, антиоксидантным и успокаивающим действием;
- способствует насыщению клеток важными, полезными элементами, содержащимися в чайных примочках;
- улучшает, восстанавливает и нормализует кровообращение;
- улучшает состояние кожи, поскольку разглаживает мелкие морщины, «гусиные лапки», тонизирует и активирует выработку коллагена;
- является источником витамина P, подходит для зрелой кожи.
Чтобы не навредить использованием чайных примочек, необходимо брать обычный крупнолистовой чай. В нем не должно быть кусочков фруктов, цедры, ароматизаторов, примесей. Нежелательно применять пакетированный или гранулированный чай, поскольку из-за содержания мелких частиц компрессы с ним могут травмировать нежную кожу вокруг глаз, попасть на слизистую органа.
Черный и зеленый чай при превышении указанного времени применения примочки могут окрасить кожу.
Состав и свойства чая
Понять, какую пользу он оказывает, можно уже при изучении состава продукта.
В него входят:
- Витамины группы B;
- Витамины C, PP, P;
- В состав чая входят эфирные масла;
- Богат он и минеральными элементами, дубильными веществами;
- Пантокриновая кислота;
- Порядка 3%-4% продукта составляет кофеин.
Какие свойства делают его таким популярным в народной косметологии?
Также чай помогает при синяках: достаточно приложить пакетик к ушибленному месту на 20 минут, и проявившийся синяк станет значительно меньше. Благодаря дубильным веществам, содержащимся в чае, кровеносные сосуды сужаются, отеки быстрее рассасываются.
Чтобы скорее свести синяк, процедуру следует проводить дважды в день.
Для любителей чая в пакетиках есть отличная новость. После использования пакетика по прямому назначению, его можно применить и в других целях. Всем известна польза чая для припухших красных глаз. Чтобы вернуть глазам нормальный вид можно приложить к ним минут на 10 пакетики черного чая, желательно, холодные, вымоченные в ледяной воде.
Среди полезных особенностей чая можно выделить его успокаивающие, антибактериальные и противовоспалительные свойства. Примечательно, что зеленые и белые сорта обладают более высоким качеством, чем черный напиток. Из действий средства можно наблюдать активную выработку коллагена, стимулирование кровотока и улучшение оттенка кожи. Также чай разгладит мелкие морщинки и вернет поверхности кожи упругость и гладкость.

В состав продукта входят эфирные масла, которые питают кожу, увлажняют ее, за счет чего она становится более упругой.
Важно учитывать некоторые особенности применения продукта, чтобы добиться прекрасных результатов. Прежде всего стоит помнить, что использовать нужно исключительно чай высокого качества. В противном случае маски для глаз будут малоэффективными
В противном случае маски для глаз будут малоэффективными
Прежде всего стоит помнить, что использовать нужно исключительно чай высокого качества. В противном случае маски для глаз будут малоэффективными.
Это еще не все рекомендации, на которые следует обращать внимание. Благодаря такой процедуре краснота и припухлость уменьшатся, глаза отдохнут и засияют с новой силой. При использовании чайной заварки для глаз следует помнить, что подходит только заварка от несладкого чая
При использовании чайной заварки для глаз следует помнить, что подходит только заварка от несладкого чая
Благодаря такой процедуре краснота и припухлость уменьшатся, глаза отдохнут и засияют с новой силой. При использовании чайной заварки для глаз следует помнить, что подходит только заварка от несладкого чая.
Если есть проблемы в ротовой полости, можно прикусить зубами чайный пакетик, предварительно вымоченный в воде. Язвочки и царапинки пройдут быстрее и будут доставлять меньше неудобств. При боли в зубах подобная процедура тоже приносит облегчение и останавливает кровотечение от вырванного зуба. Помимо того, полоскание крепким чаем прекрасно освежает дыхание.

























































